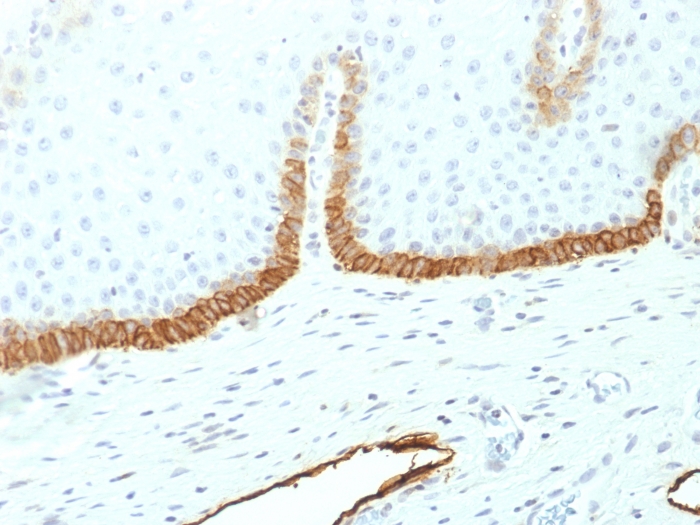
产品封面图

相关产品推荐更多 >
万千商家帮你免费找货
0 人在求购买到急需产品
- 详细信息
- 文献和实验
- 技术资料
- 免疫原:
Recombinant human Podoplanin (PDPN) protein fragment (around aa 24-126) (exact sequence is proprietary)
- 亚型:
IgG1
- 形态:
Liquid
- 保存条件:
Store as concentrated solution. Centrifuge briefly prior to opening vial. For short-term storage (1-2 weeks), store at 4ºC. For long-term storage, aliquot and store at -20ºC or below. Avoid multiple freeze-thaw cycles.
- 克隆性:
Monoclonal
- 标记物:
Unconjugated
- 适应物种:
Human
- 保质期:
12 months from the shipping date of the product.
- 抗原来源:
Human
- 目录编号:
GTX34976
- 级别:
Primary Antibodies
- 库存:
Available
- 供应商:
GeneTex
- 宿主:
Mouse
- 应用范围:
ICC/IF, IHC-P, ELISA, Protein Array
- 浓度:
0.2 mg/ml (Please refer to the vial label for the specific concentration.)
- 靶点:
Podoplanin
- 抗体英文名:
Podoplanin antibody [PDPN/1433]
- 抗体名:
Podoplanin 抗体 [PDPN/1433]
- 规格:
100 μg

IHC-P analysis of human cervix tissue using GTX34976 Podoplanin antibody [PDPN/1433].

Analysis of Protein Array containing more than 19,000 full-length human proteins using Podoplanin-Monospecific Mouse Monoclonal Antibody (PDPN/1433). Z- and S- Score: The Z-score represents the strength of a signal that a monoclonal antibody produces when binding to a particular protein on the HuProtTM array. Z-scores are described in units of standard deviations (SD’s) above the mean value of all signals generated on that array. If targets on HuProtTM are arranged in descending order of the Z-score, the S-score is the difference (also in units of SD’s) between the Z-score. S-score therefore represents the relative target specificity of a Monoclonal Antibody to its intended target. A Monoclonal Antibody is considered to specific to its intended target if the Monoclonal Antibody has an S-score of at least 2.5. For example, if a Monoclonal Antibody binds to protein X with a Z-score of 43 and to protein Y with a Z-score of 14, then the S-score for the binding of that Monoclonal Antibody to protein X is equal to 29.
风险提示:丁香通仅作为第三方平台,为商家信息发布提供平台空间。用户咨询产品时请注意保护个人信息及财产安全,合理判断,谨慎选购商品,商家和用户对交易行为负责。对于医疗器械类产品,请先查证核实企业经营资质和医疗器械产品注册证情况。
 文献和实验
文献和实验a variety of cellular sources from human olfactory epithelium (Hahn et al., 2005) and neural progenitors (Nieoullon et al., 2005) to neural stem cells (Chu et al., 2004). BrdU antibody from Abcam Identification of the labelled cells can be applied
a subset of genomic DNA sequences of type 5'-(NNN )3 -3', whereas the 6ZF library would recognize a subset of genomic sequences of type 5'-(NNN )6 -3'. Given the zinc-finger domains used, both libraries were more likely to recognize (RNN)x -type sequences
Phage‐Based Expression Cloning to Identify Interacting Proteins
the interacting protein. This technique leads directly to the isolation of a cDNA encoding the interacting protein, bypassing the need for labor?intensive protein purification, microsequencing, or antibody production.
 技术资料
技术资料暂无技术资料 索取技术资料

![Src (phospho Tyr416) antibody [EPR6239(2)]](https://img1.dxycdn.com/2022/0329/235/6300360849126020453-14.jpg!wh200)

![Insulin antibody [E2E3]](https://img1.dxycdn.com/2022/0328/840/9906891373534500453-14.jpg!wh200)

